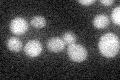
YLR070C
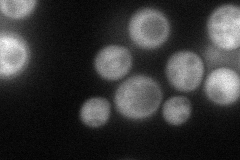
YLR070C
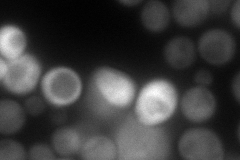
YLR070C
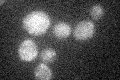
YLR070C

View description
Xylitol dehydrogenase, converts xylitol to D-xylulose; expression induced by xylose, even though this pentose sugar is not well utilized by S. cerevisiae; null mutant has cell wall defect
Localization:
Intensity:
Fold change:
Significance:
-
C’ GFP library in SD
below threshold17.54 -
N' NOP1pr-GFP in SD
cytosol81.8021 -
N' TEF2pr-mCherry in SD
cytosol104.743 -
N' NATIVEpr-GFP in SD

below threshold19.0306 -
N' TEF2pr-VC and Cyto-VN in SD

#N/A0 -
C’ GFP library in SD+DTT

cytosol14.870.84No -
C’ GFP library in SD+H2O2
cytosol16.360.93No -
C’ GFP library in Starvation Media

cytosol23.471.33No -
C’ GFP library on the background of Pup2-DaMP

below threshold -
C’ GFP library on the background of CCT mutant

below threshold16.94170.965261No
